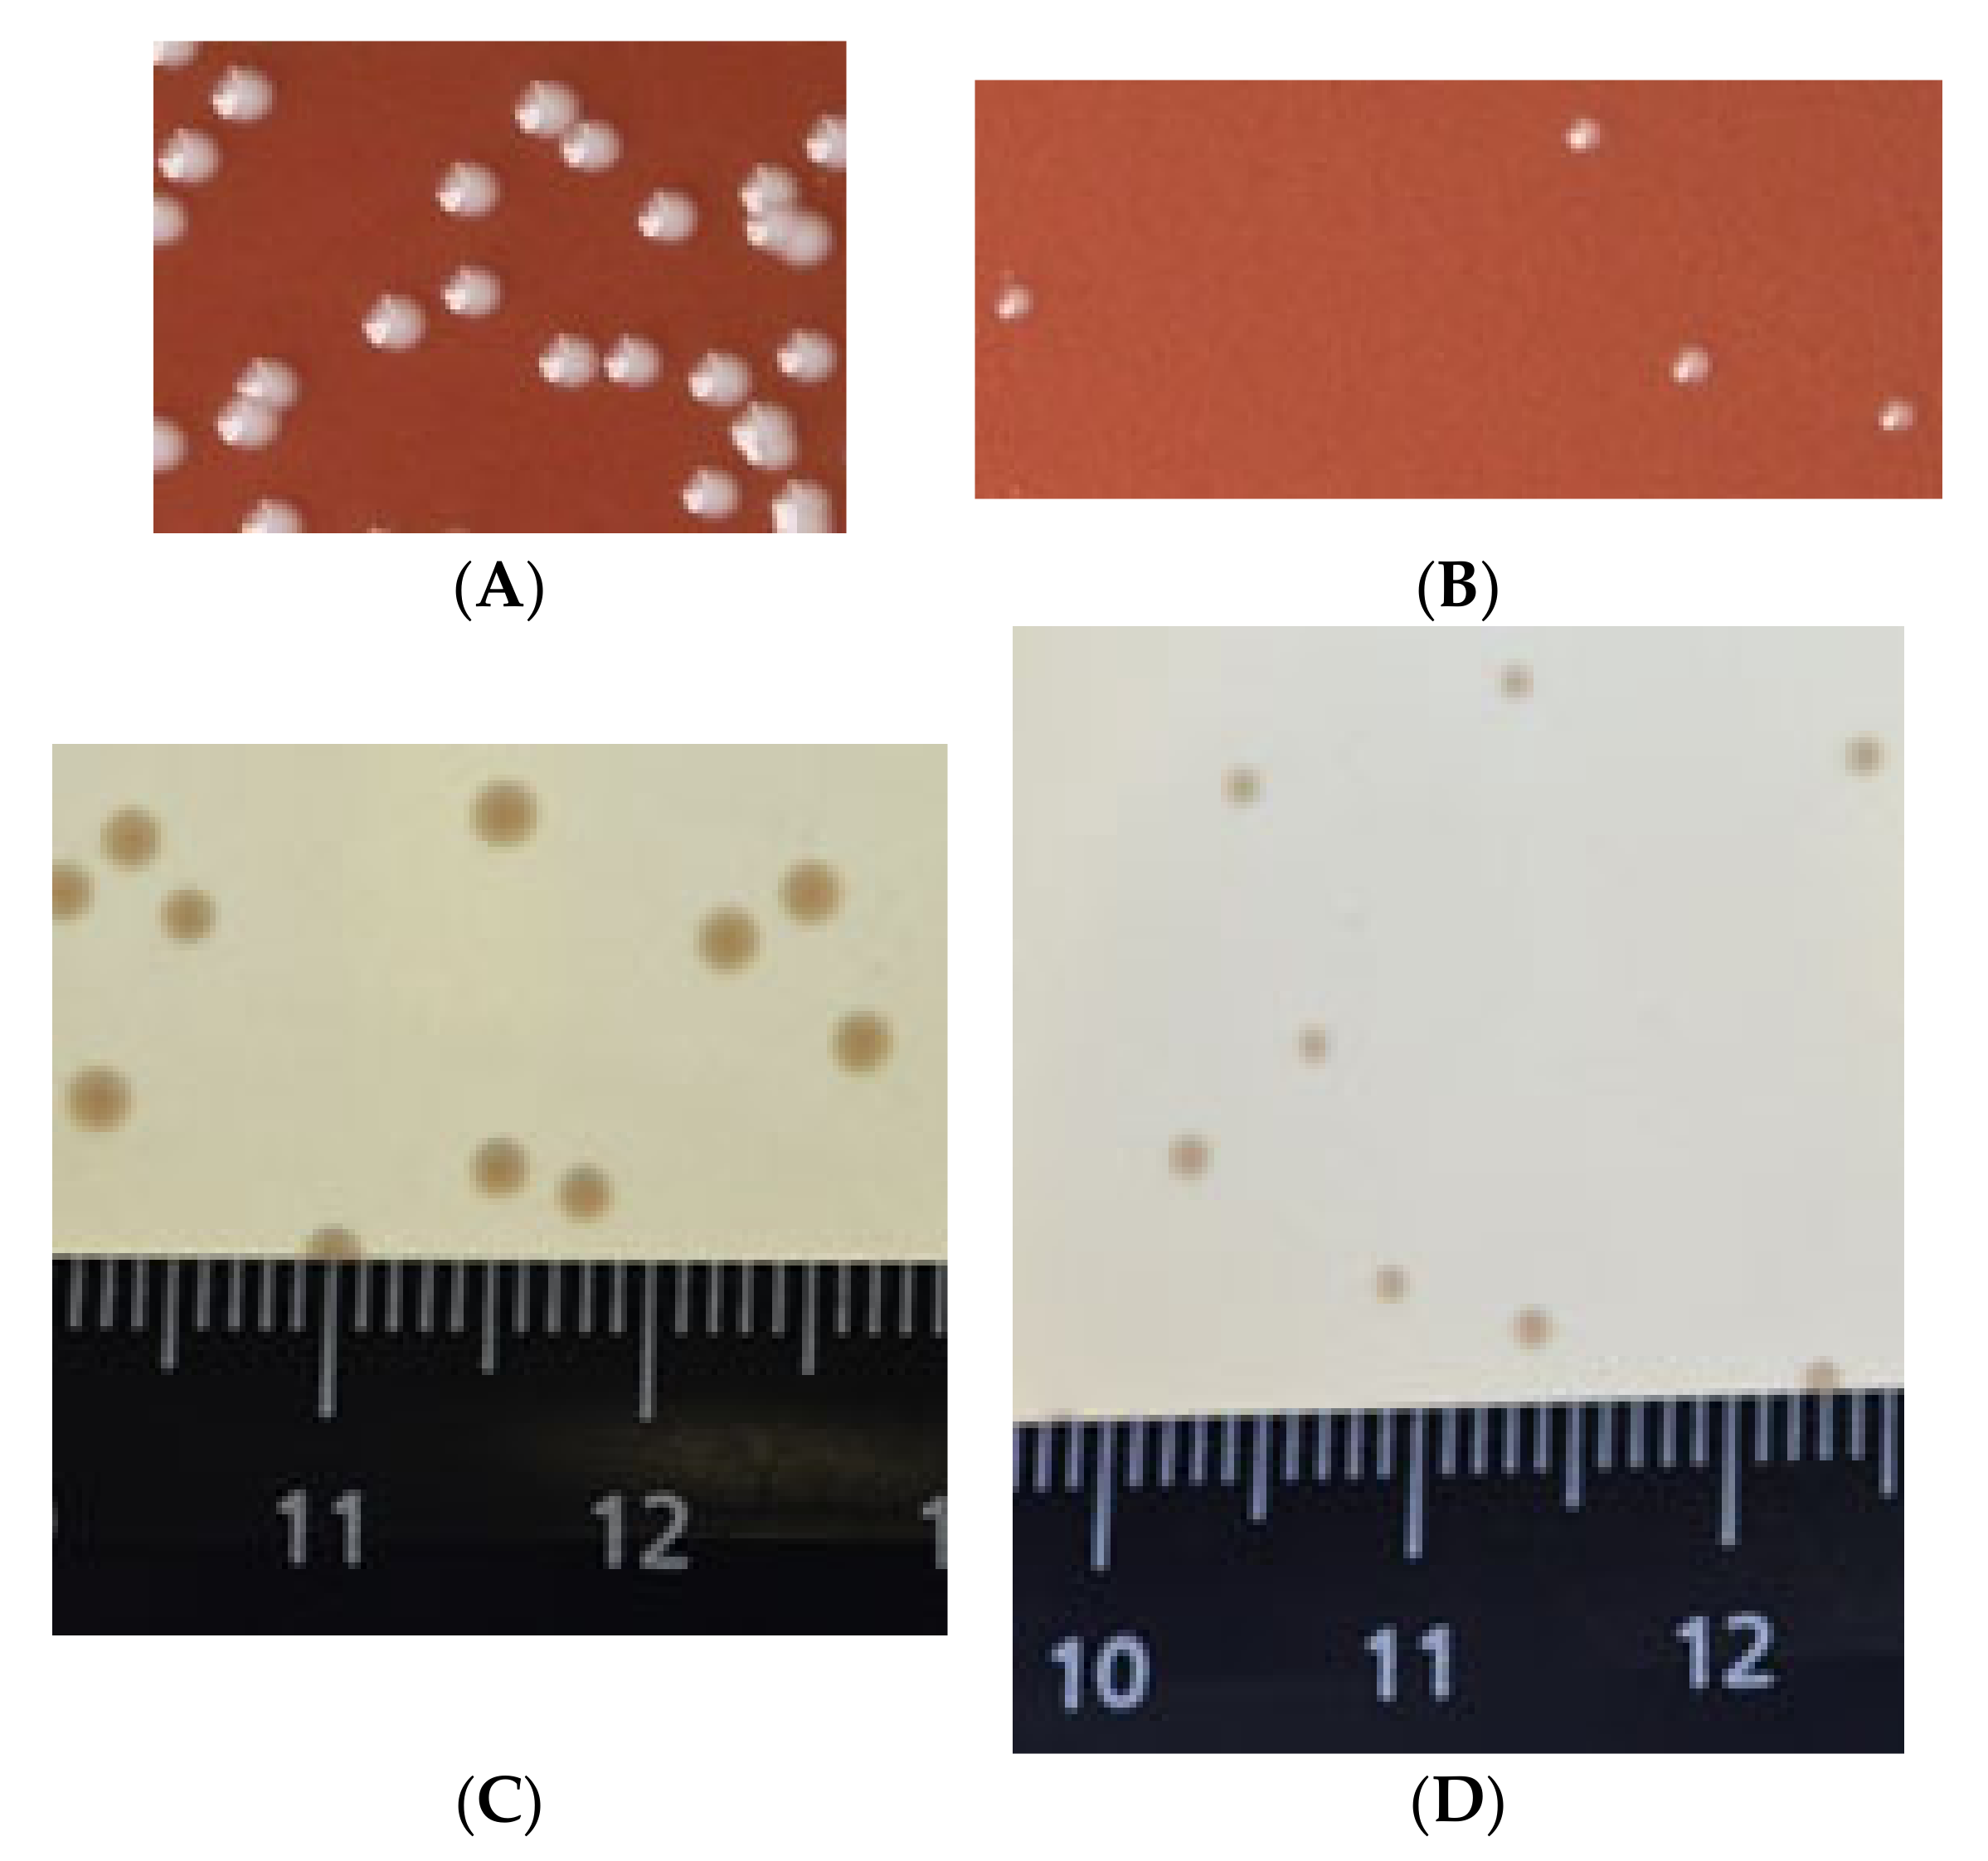
Vaccines 10 00108 g003 Vaccines 10 00108 g003

Development and Properties of Francisella tularensis Subsp. holarctica 15 NIIEG Vaccine Strain without the recD Gene
Abstract
1. Introduction
2. Materials and Methods
3. Results and Discussion
3.1. Comparative Analysis of Amino Acid Sequences RecD Proteins in the Genus Francisella
3.2. recD Deletion in F. tularensis 15 NIIEG Genome
3.3. Effects of recD on Homologous Recombination in F. tularensis
3.4. Growth of F. tularensis 15D in Nutrient Media and J774.1A Cells
3.5. recD Deletion Effects on F. tularensis Virulence
4. Discussion
Supplementary Materials
Author Contributions
Funding
Institutional Review Board Statement
Informed Consent Statement
Data Availability Statement
Acknowledgments
Conflicts of Interest
References
- Gill, V.; Cunha, B.A. Tularemia pneumonia. Semin. Respir. Infect. 1997, 12, 61–67. [Google Scholar] [PubMed]
- Dennis, D.T.; Inglesby, T.V.; Henderson, D.A.; Bartlett, J.G.; Ascher, M.S.; Eitzen, E.; Fine, A.D.; Friedlander, A.M.; Hauer, J.; Layton, M.; et al. Tularemia as a Biological Weapon: Medical and Public Health Management. J. Am. Med. Assoc. 2001, 285, 2763–2773. [Google Scholar] [CrossRef] [PubMed]
- Olsuf’ev, N.G. Taxonomy, Microbiology and Laboratory Diagnosis of the Causative agent of Tularemia; Izd. Meditsina: Moscow, Russia, 1975; 192p. (In Russian) [Google Scholar]
- Ellis, J.; Oyston, P.S.F.; Green, M.; Titball, R.W. Tularemia. Clin. Microbiol. Rev. 2002, 15, 631–636. [Google Scholar] [CrossRef]
- Medunitsyn, N.V. Vaccinology; Izd. Triada-Kh: Moscow, Russia, 1999; 272p. (In Russian) [Google Scholar]
- Eigelsbach, H.T.; Downs, C.M. Prophylactic effectiveness of live and killed tularemia vaccines. I. Production of vaccine and evaluation in the white mouse and guinea pig. J. Immunol. 1961, 87, 415–425. [Google Scholar] [PubMed]
- Sandstrom, G. The tularemia vaccine. J. Chem. Technol. Biotechnol. 1994, 59, 315–320. [Google Scholar] [CrossRef]
- Conlan, J.W.; Oyston, P.C.F. Vaccines against Francisella tularensis. Ann. N. Y. Acad. Sci. 2007, 1105, 325–350. [Google Scholar] [CrossRef]
- Smith, G.R. How RecBCD enzyme and Chi promote DNA break repair and recombination: A molecular biologist’s view. Microbiology and molecular biology reviews. Microbiol. Mol. Biol. Rev. 2012, 76, 217–228. [Google Scholar] [CrossRef]
- Woodcock, D.M.; Crowther, P.J.; Doherty, J.; Jefferson, S.; DeCruz, E.; Noyer-Weidner, M.; Smith, S.S.; Michael, M.Z.; Graham, M.W. Quantitative evaluation of Escherichia coli host strains for tolerance to cytosine methylation in plasmid and phage recombinants. Nucleic Acids Res. 1989, 17, 3469–3478. [Google Scholar] [CrossRef] [PubMed]
- Golovliov, I.; Sjostedt, A.; Mokrievich, A.; Pavlov, V. A method for allelic replacement in Francisella tularensis. FEMS Microbiol. Lett. 2003, 222, 273–280. [Google Scholar] [CrossRef]
- Iordanescu, S. Recombinant plasmid obtained from two different, compatible staphylococcal plasmids. J. Bacteriol. 1975, 124, 597–601. [Google Scholar] [CrossRef] [PubMed]
- Horinouchi, S.; Weisblum, B. Nucleotide sequence and functional map of pC194, a plasmid that specifies inducible chloramphenicol resistance. J. Bacteriol. 1982, 150, 815–825. [Google Scholar] [CrossRef] [PubMed]
- Pomerantsev, A.P.; Domaradskii, I.V.; Doronin, I.P.; Fursov, V.V. Investigation of cat-gene expression of plasmids Sa and pC194 in Escherichia coli, Francisella tularensis and Bacillus subtilis cells. Mol. Gen. Mikrobiol. Virusol. 1991, 9, 21–24. (In Russian) [Google Scholar] [PubMed]
- Primrose, S.B.; Ehrlich, S.D. Isolation of plasmid deletion mutants and study of their instability. Plasmid 1981, 6, 193–201. [Google Scholar] [CrossRef]
- Mokrievich, A.N.; Vakhrameeva, G.M.; Titareva, G.M.; Bakhteeva, I.V.; Mironova, R.I.; Kombarova, T.I.; Kravchenko, T.B.; Dyatlov, I.A.; Pavlov, V.M. Construction and characterization of Francisella tularensis vaccine strain with a single copy of iglC gene and lacking recA gene. Mol. Gen. Microbiol. Virol. 2015, 30, 148–156. [Google Scholar] [CrossRef]
- Yanisch-Perron, C.; Vieira, J.; Messing, J. Improved M13 phage cloning vectors and host strains: Nucleotide sequences of the M13mp18 and pUC19 vectors. Gene 1985, 33, 103–119. [Google Scholar] [CrossRef]
- Bakshi, C.S.; Malik, M.; Regan, K.; Melendez, J.A.; Metzger, D.W.; Pavlov, V.M.; Sellati, T.J. Superoxide dismutase B gene (sodB)-deficient mutants of Francisella tularensis demonstrate hypersensitivity to oxidative stress and attenuated virulence. J. Bacteriol. 2006, 188, 6443–6448. [Google Scholar] [CrossRef]
- Miller, D. Experiments in Molecular Genetics; Cold Spring Harbor Laboratory: Cold Spring Harbor, NY, USA, 1972. [Google Scholar]
- Sambrook, J.; Fritsch, E.F.; Maniatis, T. Molecular Cloning: A Laboratory Manual, 2nd ed.; Cold Spring Harbor Laboratory Press: Cold Spring Harbor, NY, USA, 1989. [Google Scholar]
- Pavlov, V.M.; Mokrievich, A.N.; Volkovoy, K. Cryptic plasmid pFNL10 from Francisella novicida-like F6168, The base of plasmid vectors for Francisella tularensis. FEMS Immunol. Med. Microbiol. 1996, 13, 253–256. [Google Scholar] [CrossRef] [PubMed]
- Mokrievich, A.N.; Vakhrameeva, G.M.; Mironova, R.I.; Kombarova, T.I.; Titareva, G.M.; Kravchenko, T.B.; Bakhteeva, I.V.; Dyatlov, I.A.; Pavlov, V.M. Construction and Investigation of the Vaccine Strain Francisella tularensis without iglC genes. Commun. 1. Probl. Osobo Opasnykh Inf. 2013, 117, 70–74. (In Russian) [Google Scholar] [CrossRef]
- Shishkova, N.A.; Vakhrameyeva, G.M.; Pavlov, V.M.; Mokrievich, A.N.; Dyatlov, I.A. Plazmida cryotransformation of vaccin strain Francisella tularensis 15 NIIEG. Bacteriology 2018, 3, 38–42. (In Russian) [Google Scholar] [CrossRef]
- National Research Council. Guide for the Care and Use of Laboratory Animals, 8th ed.; National Academy Press: Washington, DC, USA, 2010; 220p. [Google Scholar]
- Lapin, A.A.; Mokrievich, A.N.; Vakhrameeva, G.M.; Kombarova, T.I.; Bakhteeva, I.V.; Dyatlov, I.A.; Pavlov, V.M. Immunobiological properties of Francisella tularensis 15/10 strain with deleted recA gene. Probl. Osobo Opasn. Infekts. 2011, 110, 65–67. (In Russian) [Google Scholar] [CrossRef]
- Cano, D.A.; Pucciarelli, M.G.; Portillo, F.G.; Casadesús, J. Role of the RecBCD Recombination Pathway in Salmonella Virulence. J. Bacteriol. 2002, 184, 592–595. [Google Scholar] [CrossRef] [PubMed]
- Amundsen, S.K.; Taylor, A.F.; Smith, G.R. The RecD subunit of the Escherichia coli RecBCD enzyme inhibits RecA loading, homologous recombination, and DNA repair. Proc. Natl. Acad. Sci. USA 2000, 97, 7399–7404. [Google Scholar] [CrossRef] [PubMed]
- Taylor, A.F.; Smith, G.R. RecBCD enzyme is a DNA helicase with fast and slow motors of opposite polarity. Nature 2003, 423, 889–893. [Google Scholar] [CrossRef]
- Hazlet, K.R.O.; Caldon, S.D.; McArthur, D.G.; Cirillo, K.A.; Kirimanjeswara, G.S.; Magguilli, M.L.; Malik, M.; Shah, A.; Broderick, S.; Golovliov, I.; et al. Adaptation of Francisella tularensis to the mammalian environment is governed by cues which can be mimicked in vitro. Infect. Immun. 2008, 76, 4479–4488. [Google Scholar] [CrossRef] [PubMed]
- Hazlet, K.R.O.; Cirillo, K.A. Environmental adaptation of Francisella tularensis. Microbes. Infect. 2009, 11, 828–834. [Google Scholar] [CrossRef][Green Version]
- Holland, K.M.; Rosa, S.J.; Kristjansdottir, K.; Wolfgeher, D.; Franz, B.J.; Zarrella, T.M.; Kumar, S.; Sunagar, R.; Singh, A.; Bakshi, C.S.; et al. Differential growth of Francisella tularensis, which alters expression of virulence factors, dominant antigens, and surface-carbohydrate synthases, governs the apparent virulence of Ft SchuS4 to immunized animals. Front. Microbiol. 2017, 8, 1158. [Google Scholar] [CrossRef] [PubMed]
- Regha, K.; Satapathy, A.K.; Ray, M.K. RecD Plays an Essential Function During Growth at Low Temperature in the Antarctic Bacterium Pseudomonas syringae Lz4W. Genetics 2005, 170, 1473–1484. [Google Scholar] [CrossRef]
- Larsson, P.; Oyston, P.C.F.; Chain, P.; Chu, M.C.; Duffield, M.; Fuxelius, H.-H.; Garcia, E.; Hälltorp, G.; Johansson, D.; Isherwood, K.E.; et al. The complete genome sequence of Francisella tularensis the causative agent of tularemia. Nat. Genet. 2005, 37, 153–159. [Google Scholar] [CrossRef]

| Name | Description | Source or Reference |
|---|---|---|
| Strains | ||
| E. coli DH5α | F- (φ80dlacZΔM15) recA1 endA1 gyrA96 thi-1 hsdR17(rk–mk+) supE44 relA1 deoR Δ(lacZYA-argF) U169 | GKPM-Obolensk * [10] |
| E. coli S17-1 λpir | (thi pro hsdR– hsdM+ recA RP4-2-Tc::Mu-Km::Tn7(TpR SmR)) | GKRM-Obolensk [11] |
| E. coli S17(pHVmob) | AmpR, CmR, a derivative of S17-1 λpir containing pHVmob plasmid | This paper |
| E. coli DH5α(pGM∆recD) | AmpR, CmR, SucS, derivative of DH5α, pGM∆recD plasmid | This paper |
| E. coli DH5α (pUK194) | AmpR KmR derivative of DH5α containing pUK194 plasmid | This paper |
| E. coli DH5α(pUK/recD) | AmpR KmR derivative of DH5α with pUK194 plasmid, a fragment of the F. tularensis genome with the recD gene | This paper |
| E. coli DH5α(pGM∆sodC) | AmpR, CmR, SucS, derivative of DH5α containing pGM∆sodC plasmid | This paper |
| E. coli S17(pPV∆glC) | AmpR, CmR, SucS, derivative of S17-1 λpir containing pPV∆iglC plasmid, | GKRM-Obolensk [11] |
| F. tularensis 15 NIIEG | PmR, AmpR, subsp. holarctica, a vaccine strain | GKPM-Obolensk |
| F. tularensis 15D | PmR, a modified F. tularensis 15 NIIEG strain with the recDgene deleted | This paper |
| F. tularensis 15D(pHVmob) | PmR, CmR F. tularensis 15D with pHVmob plasmid | This paper |
| F. tularensis 15(pK194) | KmR, a F. tularensis 15 NIIEG strain with pK194 plasmid, | This paper |
| F. tularensis 15D(pUK194) | PmR, a F. tularensis 15D strain with pUK194 plasmid | This paper |
| F. tularensis 15D(pUK/recD) | PmR, a F. tularensis 15D with pUK/recD plasmid containing a fragment of the F. tularensis genome with the recD gene | This paper |
| Plasmids | ||
| pC194 | CmR. Replicates autonomously in F. tularensis cells | [12,13,14] |
| pHV33 | AmpR, CmR | [15] |
| pHVmob | AmpR, CmR, pHV33 plasmid containing a 1.7-kb fragment of RP4 plasmid with a mob region | This paper |
| pGM5 | AmpR, CmR, sacB. | [16] |
| pGM∆recD | AmpR, CmR, sacB, pGM5 plasmid with a modified 2.9-kb fragment of the F. tularensis 15 NIIEG genome, 603 bps deleted from the recD gene | This paper |
| pK194 | KmR, derivative of pC194 plasmid with the cat gene replaced by KmR from the mTn10Km transposon. Replicates autonomously in F. tularensis cells | This paper |
| pUC19 | AmpR | [17] |
| pUK194 | AmpR KmR cointegrate of pUC19 and pK194 plasmids at the HindIII site. | This paper |
| pUK/recD | AmpR KmR, pUK194 plasmid with a 3.5-kb fragment of the F. tularensis genome containing the recD gene | This paper |
| pPV∆iglC | AmpR, CmR, sacB, pPV plasmid with a 3.0-kb fragment of the F. tularensis 15 NIIEG genome, 545 bps deleted from the iglC gene | [11] |
| pGM∆sodC | AmpR, CmR, sacB, pGM5 plasmid with a modified 1.7-kb fragment of the F. tularensis 15 NIIEG genome, 528 bps deleted from the sodC gene | This paper |
| Name | Sequence 5′-3′ a,b | Primer Localization |
|---|---|---|
| For recD deletion | ||
| Amplicon upstream the recD gene | ||
| FSD | AAAgtcgacTGGCAAAGATGATAGTGT | forward primer with a SalI site |
| RBD | AAAggatccTTACATAGACGGAGTAGTCT | reverse primer with a BamHI site |
| Amplicon downstream the recD gene | ||
| FBD | AAAggatccTAAGCTCAGAGAATGACAGA | forward primer with a BamHI site |
| RSD | AAAgtcgacGTGCTATCCTACCAGG | reverse primer with a SalI site |
| Amplicon to control recD deletion | ||
| FCD | GATGGTTATGGAGTTTATCGAGC | forward primer |
| RCD | TAAGAGCCTCTTTGTAGTCACGG | reverse primer |
| For sodC deletion | ||
| Amplicon upstream the sodC gene | ||
| sodCL-F | AAAgtcgacAACGACAGCATATTGCCACTCATAG | forward primer with a SalI site |
| sodCL-R | AAAggatccCACCTCCAAAATTTAGGTCATATC | reverse primer with a BamHI site |
| Amplicon downstream the sodC gene | ||
| sodCR-F | AAAggatccGTGCTAGAATGTGGTGTGGAGTTA | forward primer with a BamHI site |
| sodCR-R | AAAgtcgacCATATCAATATGACCTTTCTTTGGC | reverse primer with a SalI site |
| Amplicon to control sodC deletion | ||
| sodC-KF | CGTATCAGCTAAAGTGATAATCGGT | forward primer |
| sodC-KR | GACAAAATACTGCAACACCAACAGC | reverse primer |
| F. Tularensis Strain | CmR Clones Per Recipient Cell | |
|---|---|---|
| pPV/∆iglC | pGM/∆sodC | |
| 15D | <1 × 10−9 | <1 × 10−9 |
| 15 NIIEG | 1 × 10−7 | 1 × 10−6 |
| 15D(pUK/recD) | 1 × 10−6 | 1 × 10−6 |
| 15D(pUK194) | <1 × 10−9 | <1 × 10−9 |
| F. Tularensis Strain | CmR Clones Per Recipient Cell | |
|---|---|---|
| Mobilization Efficiency (Per Recipient Cell) | Cryotransformation Efficiency (CFUμg DNA) | |
| 15D | 3 × 10−2 | 1 × 106 |
| 15 NIIEG | 3 × 10−2 | 1 × 106 |
| 15D (pUK/recD) | 3 × 10−2 | 1 × 106 |
| 15D (pUK194) | 3 × 10−2 | 1 × 106 |
| F. Tularensis Strain | Challenge Dose | Survival (%) |
|---|---|---|
| 15D | 1 × 103 | 100 |
| 1 × 105 | 100 | |
| 15D(pUK/recD) | 8 × 102 | 0 |
| 8 × 104 | 0 | |
| 15D (pUK194) | 6 × 102 | 100 |
| 6 × 104 | 100 | |
| 15 NIIEG | 1 × 102 | 30 |
| 1 × 103 | 0 |
Publisher’s Note: MDPI stays neutral with regard to jurisdictional claims in published maps and institutional affiliations. |
© 2022 by the authors. Licensee MDPI, Basel, Switzerland. This article is an open access article distributed under the terms and conditions of the Creative Commons Attribution (CC BY) license (https://creativecommons.org/licenses/by/4.0/).
Share and Cite
Pavlov, V.; Vakhrameeva, G.; Mokrievich, A.; Platonov, M.E.; Titareva, G.; Mironova, R.; Kombarova, T.; Gapelchenkova, T.; Dyatlov, I. Development and Properties of Francisella tularensis Subsp. holarctica 15 NIIEG Vaccine Strain without the recD Gene. Vaccines 2022, 10, 108. https://doi.org/10.3390/vaccines10010108
Pavlov V, Vakhrameeva G, Mokrievich A, Platonov ME, Titareva G, Mironova R, Kombarova T, Gapelchenkova T, Dyatlov I. Development and Properties of Francisella tularensis Subsp. holarctica 15 NIIEG Vaccine Strain without the recD Gene. Vaccines. 2022; 10(1):108. https://doi.org/10.3390/vaccines10010108
Chicago/Turabian StylePavlov, Vitaly, Galina Vakhrameeva, Alexander Mokrievich, Mikhail E. Platonov, Galina Titareva, Raisa Mironova, Tatiana Kombarova, Tatiana Gapelchenkova, and Ivan Dyatlov. 2022. "Development and Properties of Francisella tularensis Subsp. holarctica 15 NIIEG Vaccine Strain without the recD Gene" Vaccines 10, no. 1: 108. https://doi.org/10.3390/vaccines10010108
APA StylePavlov, V., Vakhrameeva, G., Mokrievich, A., Platonov, M. E., Titareva, G., Mironova, R., Kombarova, T., Gapelchenkova, T., & Dyatlov, I. (2022). Development and Properties of Francisella tularensis Subsp. holarctica 15 NIIEG Vaccine Strain without the recD Gene. Vaccines, 10(1), 108. https://doi.org/10.3390/vaccines10010108

